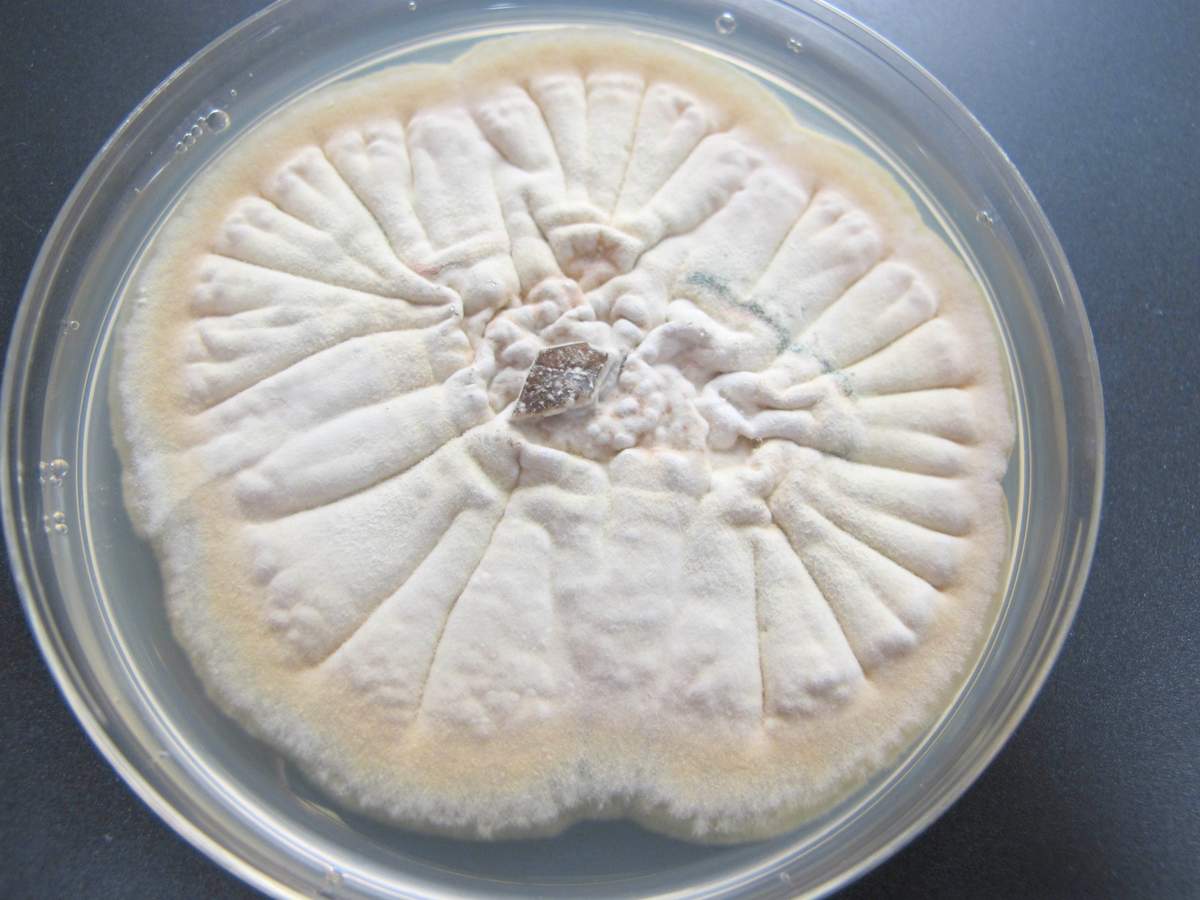

פטריות עובש היו קיימות על פני כדור הארץ הרבה לפני הופעת האנושות. אלה הם אורגניזמים עמידים מאוד הנחוצים לקיום התקין של המערכת האקולוגית הטבעית. פטריות עובש אינן בטוחות לבני אדם, מכיוון שהן עלולות להוביל למוות. אך יחד עם זאת, הם מועילים לאנושות. מינים מסוימים משמשים ברפואה לייצור אנטיביוטיקה ומצילים אנשים ממחלות.
תוכן
סוגי התבניות ותיאורן עם תמונות
פטריות עובש נקראות מיקרומיציטים. יש להם מבנה מיקרוסקופי, המיוצג על ידי גוף-מיסליום מרובה שורות דק מאוד. הגוף מסועף, מכיל לעתים רחוקות מחיצות, הוא הבסיס של מוליציום רב-קולי. ניתן לראות פרטים על המבנה בתמונה.
מאפיינים של עובש הם תכונות כאלה:
- המיסיליום הוא הבסיס לגוף הווגטטיבי - hyphae ענפי נימה.
- גודל גדול של mycelium.
- המיסיליום, שלא כמו שמרים, מחולק לתאים.
- אפשרות להתרבות בשלושה אופנים: צמחתי, לא מיני, מיני.
ישנן כמה סיווגים של עובש. הסיווג הנפוץ ביותר הוא צבע (פטריות הן לבן, צהוב, שחור, ירוק, חום, אדום) וסיווג לפי מספר התאים.
 אתה עשוי להתעניין ב:
אתה עשוי להתעניין ב:לפי מספר התאים, עובש מחולק לשני סוגים: זיגומיציטים ואסקומציטים. זיגומציטים הם קבוצה קטנה של פטריות חד-תאיות. Ascomycetes הם רב תאיים.
המיקולוגים מבחינים ב -4 סוגים של עובשים:
- אספרגילוס.
- בוטריטיס.
- פניצילוס
- Hypomyces.
לסוג אספרגילוס יש כמה מאות מינים. למיסליום שלו יש מחיצות האופייניות לפטריות גבוהות יותר. בתחילה, לעובש צבע לבן, אך ככל שהיא מתבגרת היא רוכשת מגוון רחב של גוונים. ההתרבות של מינים אספרגילוס מתרחשת באופן הא-מיני המסורתי, אך כמה מינים גבוהים יותר מסוגלים להתרבות מינית.
מינים רבים של אספרגילוס מסוכנים לבריאות האדם. הם יכולים לגרום למחלות קשות אצל אנשים. סוגים שונים משמשים באופן פעיל בתעשיית המזון והרפואה.
 אתה עשוי להתעניין ב:
אתה עשוי להתעניין ב:בוטריטיס נקרא בדרך כלל עובש אפור. פטריות יוצרות מושבות עבות וחסרות צבע, אשר עקב צפיפותן רוכשות גוון אפור מעושן. נציגי הבוטריטיס הם פטריות חד תאיות המשתקעות באדמה ועל שרידי צמחים.
GIFs גלויים לעין בלתי מזוינת. מינים מסוג זה משתנים מאוד, ולכן הם יכולים ללבוש צורות מגוונות. נציגי הבוטריטיס הכרחיים בייצור יינות. הם אינם נושאים סכנה מסוימת לבני אדם. מינים של בוטריטיס יכולים להיות מושפעים מפטריות hyperparasitic.
פניצילום נחשב לתבנית אצילית. הוא משמש באופן פעיל ברפואה המסורתית, כמו גם בייצור גבינות וייצור נקניקיות. ישנן 4 קבוצות מינים מהסוג הפניצילוס:
- קטיפתי;
- הרגיש;
- צרור;
- מינים עם קורמיות.
מינים של הסוג פניציל מתיישבים באדמה, מים ואוויר. רבים מהם מעדיפים צמחים ומזונות.בהתאם למין, צבע התבנית משתנה. לרוב זה לבן, צהוב, כתום או חום. מקרים של אדום ושחור פחות נפוצים.
חלב Hypomyces מתייחס לעובש אכיל. מין זה של פלסנביך חי על פטריות אכילות - רוסולה וחלב.

בתחילה, התבנית באה לידי ביטוי בציפוי דק של גוון אדום בהיר או כתום בהיר. ואז על זה מתחילים להיווצר כיתות - גופים בצורת נורה שניתן לצפות בהם דרך זכוכית מגדלת.
היפומיקוזיס חלב נחשב למעדן. קוטפי פטריות קוראים לזה לובסטר פטריות לצבע שדומה לצבע לובסטר, מבושל וטעם הדומים להשוואה לפירות ים. לובסטר פטריות לא נאכל סתם - הוא ציד אמיתי עבורו. מין זה אינו מהווה שום איום על חיי האדם ובריאותו.
השימוש בתבניות על ידי בני אדם
פטריות עובש משמשות באופן פעיל על ידי בני אדם בתחומי תעשיה שונים, החל בייצור מוצרי מזון ומסתיימים בייצור תרופות. השימוש הנפוץ ביותר בסוגי עובש אלה:
- זנים אספרגילוס ניגר משמשים לייצור חומצת לימון.
- זנים של הסוג בוטריטיס משמשים באופן פעיל בייצור יינות והכנת משקאות אלכוהוליים אחרים.

זרעי בוטריטיס על גרגרי יער - כמה סוגים של עובש אצילי משמשים לייצור זנים מיוחדים של גבינה (רוקפור, קממבר) ונקניקיות מעושנות לא מבושלות.
- נציגי הסוג פניצילוס הם המרכיב הבסיסי בתרופות בקבוצת הפניצילין. לתרופות מסוג זה השפעות אנטיביוטיות וחיידקיות. תרופות בקבוצת הפניצילין נמצאות בשימוש נרחב ברפואה המסורתית.
נזק לעובש
למרות היתרונות, עובש יכול להזיק מאוד. המסוכנים ביותר הם נציגי הסוג של אספרגילוס. הם מסוגלים להדביק בני אדם ובעלי חיים. הנפוצים ביותר הם נגעי עור, דלקות באוזן החיצונית, תגובות אלרגיות. מחלה קשה בשם mycetoma מעוררת עובש מסוג זה.
הסוג בוטריטיס יכול להיקרא בבטחה מזיק בגינה.
נציגי מין זה גורמים למספר רב של מחלות פטרייתיות בצמחים כאלה:
- תותי בר;
- ענבים;
- בצל;
- כמה גידולי שורשים;
- פירות הדר;
- צללית;
- שעועית
- פשתן;
- סלט;
- אפונה.
אצל בני אדם, בוטריטיס מעוררת אלרגיה. לעיתים נבגים פטרייתיים גורמים למחלות ריאה אצל אנשים המועדים למחלות נשימה.
תנאי טיפוח
עובש נפוץ מאוד. הם צומחים על פני כמעט כל כדור הארץ ויוצרים מושבות ענקיות. בית הגידול של העובש עשוי להיות אוויר, אדמה ומים. הם מתיישבים על אוכל, צמחים.
מטרת המושבה היא ספיגת כל חומרי התזונה. לאחר הידלדלות מקור הכוח של המושבה, מתחיל התהליך האקטיבי של היווצרות נבגים. נבגים בוגרים מתפשטים למקומות חדשים העשירים בחומרים מזינים, ומיסיליום ישן נשאר במקור מת.

עובש הוא לא יומרני לחלוטין לסביבה החיצונית ומתפתח ללא קשר לתנאיו. אך התנאים הנוחים ביותר הנחוצים לחיים והתפתחות פטריות נחשבים כדלקמן:
- שפע הפחמימות.
- טמפרטורה גבוהה.
- לחות גבוהה.
תבניות אוהבות להתיישב על מצעים עשירים בעמילן. יש מדענים הטוענים כי התבניות אינן מעובדות באור שמש בהיר. זה לא לגמרי נכון. הם אוהבים את רמת הלחות הגבוהה, ואור שמש ישיר מייבש אותה. לכן פטריות לא מתפתחות היטב מתחתיהן. אבל אור בהיר או צל חלקי מלווים לחות - זה לא ממלא שום תפקיד.
 אתה עשוי להתעניין ב:
אתה עשוי להתעניין ב:תשובות לשאלות נפוצות
תבנית כזו המוכרת לכולם כיום היא נושא המחלוקת בקרב מדענים. אנשים מחפשים בעקשנות את כל האפשרויות והיכולות החדשות של עובש, מאשימים אותה במחלות רבות ומעניקים להם תכונות רפואיות מופלאות. להלן התשובות לשאלות הנפוצה ביותר בנושא עובש:
מיני עובש הם מגוונים מאוד. היתרונות של פטריות אלה לאנושות לא יסולא בפז. אך מינים מסוימים מהווים סכנה חמורה לבני אדם.

טיפול ושימוש בקומבוצ'ה בבית (+22 תמונה)
טיפול ושימוש בקומבוצ'ה בבית (+22 תמונה) אכילות של פטריית המטרייה הקשה והתיאור שלה (תמונה +19)
אכילות של פטריית המטרייה הקשה והתיאור שלה (תמונה +19) תיאור שמנים אכילים ובלתי אכילים, עמיתיהם הרעילים (40 תמונות)
תיאור שמנים אכילים ובלתי אכילים, עמיתיהם הרעילים (40 תמונות) תכונות שימושיות של פטריות חלב והתוויות נגד שלה (+17 תמונות)
תכונות שימושיות של פטריות חלב והתוויות נגד שלה (+17 תמונות)